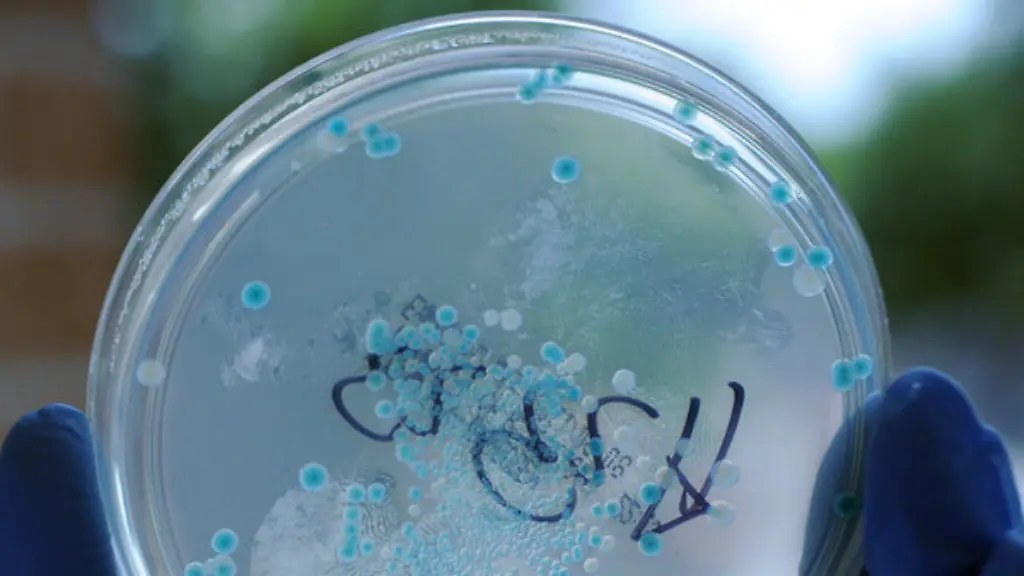
In-den-USA-werden-jaehrlich-hoechstens-500-Elizabethkingia-Infektionen-registriert

US-Staat WisconsinInfektionswelle fordert 18 Todesopfer
Fieber und Atemnot sind zwei bekannte Symptome einer Infektion mit dem "Elizabethkingia"-Bakterium. Im US-Staat Wisconsin erkranken daran 44 Menschen, 18 sterben. Nun schaltet sich die Nationale Gesundheitsbehörde ein.
Eine mysteriöse Infektionswelle beschäftigt die Behörden im US-Staat Wisconsin. 44 Menschen sind dort seit Anfang November an einer Infektion mit dem Bakterium Elizabethkingia anophelis erkrankt, wie die Gesundheitsbehörde des Staates mitteilte. 18 Menschen starben nach einem Bericht von "Fox News 6".
Allerdings müssen die Todesfälle nicht zwingend auf die Bakterien zurückgehen, da die meisten Patienten über 65 Jahre alt waren und bereits zuvor an mindestens einer schweren Krankheit litten. Was genau die aktuelle Infektionswelle auslöste, ist noch unklar. Andere Staaten sind anscheinend nicht betroffen.
"Wir konnten noch keine Gemeinsamkeit zwischen den Fällen feststellen", sagte die zuständige Amtsärztin Karen McKeown dem "Wisconsin State Journal". Für eine Übertragung von Mensch zu Mensch gebe es aber keine Hinweise. Mittlerweile unterstützt die Nationale Gesundheitsbehörde CDC die Behörden vor Ort bei der Suche nach der Ursache.
In der Regel werden in den gesamten USA jährlich höchstens 500 Fälle von "Elizabethkingia"-Infektionen registriert. Symptome sind unter anderem Fieber und Atemnot. Benannt ist sie nach der US-amerikanischen Bakteriologin Elizabeth King, die die Keime 1959 erstmals beschrieb.